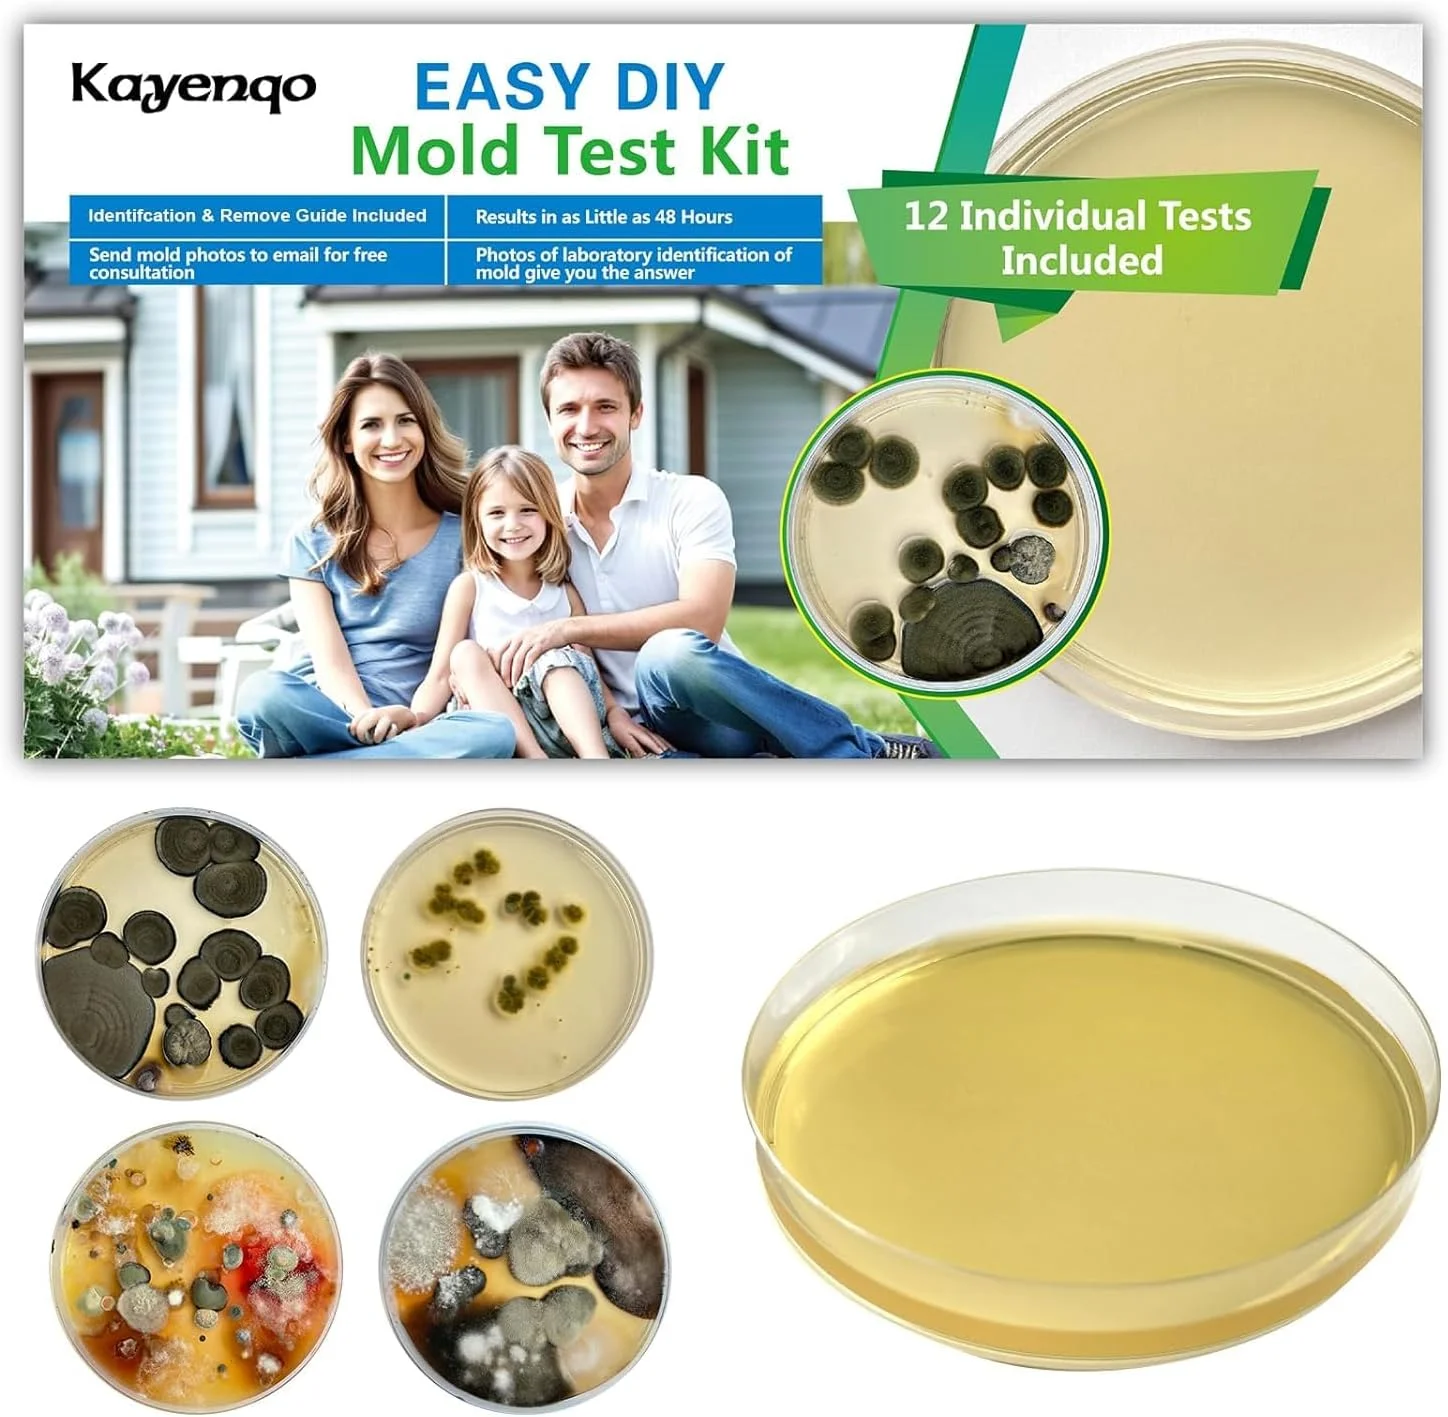
کیت تست کپک برای خانه - 12 تست تشخیص ساده، تست سیستم تهویه مطبوع، سطوح خانه و کیت های تست کیفیت هوای داخلی، آشکارساز کپک DIY در خانه، شامل راهنمای شناسایی دقیق کپک، تست کننده هوا کیت تست کپک برای خانه - 12 تست تشخیص ساده، تست سیستم تهویه مطبوع، سطوح خانه و کیت های تست کیفیت هوای داخلی، آشکارساز کپک DIY در خانه، شامل راهنمای شناسایی دقیق کپک، تست کننده هوا

تجهیزات سلامت محیط
فیلترها
تجهیزات سلامت محیط یکی از کلیدی ترین ابزارها برای حفظ بهداشت و ارتقای کیفیت زندگی در فضاهای عمومی و خصوصی به شمار می روند. چه در محیط های درمانی، چه در اداره ها و حتی خانه ها، استفاده از این تجهیزات می تواند نقش مؤثری در کاهش آلودگی، جلوگیری از بیماری ها و ایجاد فضایی ایمن تر ایفا کند. از دستگاه های تصفیه هوا گرفته تا ضدعفونی کننده های سطحی و هشداردهنده های کیفیت هوا، همه و همه در یک هدف مشترک خلاصه می شوند: محافظت از سلامت ما.
تکنولوژی در خدمت پاکیزگی: ویژگی های کلیدی تجهیزات سلامت محیط
تجهیزات سلامت محیط از لحاظ فنی طیف متنوعی از امکانات را شامل می شوند. این محصولات معمولاً دارای فیلترهای HEPA، سنسورهای تشخیص آلودگی، نمایشگر دیجیتال کیفیت هوا، قابلیت اتصال به اپلیکیشن و کنترل از راه دور هستند. دستگاه های تصفیه هوا در ابعاد مختلف عرضه می شوند؛ از مدل های رومیزی گرفته تا دستگاه های ایستاده با توان بالا برای سالن ها و بیمارستان ها. برخی از این تجهیزات مجهز به لامپ UV-C برای از بین بردن باکتری ها و ویروس ها نیز هستند. رنگ بندی اغلب آن ها خنثی و مینیمال است تا با هر دکوراسیونی همخوانی داشته باشد. وزن سبک و طراحی ارگونومیک نیز حمل و نصب آن ها را آسان کرده است.
چه تجهیزاتی برای شما مناسب است؟ راهنمای انتخاب تجهیزات سلامت محیط
در انتخاب تجهیزات سلامت محیط باید به چند فاکتور مهم توجه کرد. ابتدا باید محیط استفاده را مشخص کرد؛ آیا قرار است در فضای خانگی استفاده شود یا در محیط های درمانی و عمومی؟ سپس نوع نیاز، یعنی حذف ذرات معلق، بوی نامطبوع، رطوبت یا باکتری های موجود در هوا باید شناسایی شود. کیفیت ساخت و برند نیز اهمیت دارد، چرا که این تجهیزات در صورت عملکرد ضعیف، نه تنها فایده ای ندارند بلکه ممکن است مضر هم باشند. همچنین به توان مصرفی، صدای تولیدی دستگاه و خدمات پس از فروش نیز دقت کنید. محصولی که به خوبی نیاز شما را پوشش دهد، بهترین انتخاب است.
چرا تجهیزات سلامت محیط انتخاب بهتری هستند؟
تجهیزات سلامت محیط در مقایسه با محصولات مشابه، چندین مزیت قابل توجه دارند. اولین مزیت، تنوع عملکرد آن هاست؛ بسیاری از این تجهیزات چندمنظوره هستند و هم زمان هوا را تصفیه، رطوبت را تنظیم و باکتری ها را از بین می برند. دومین مزیت، دقت بالای سنسورها و کنترل هوشمند است که باعث صرفه جویی در مصرف انرژی می شود. نسبت به دستگاه های قدیمی تر یا مدل های ارزان قیمت، این تجهیزات با تکنولوژی روز هماهنگ تر هستند و عمر طولانی تری نیز دارند. طراحی زیبا، صدای کم و نگهداری آسان نیز از دیگر نقاط قوت آن ها به شمار می رود. در مجموع، ارزش خرید تجهیزات سلامت محیط بسیار بالاست.
مدل های مختلف تجهیزات سلامت محیط؛ کدام را انتخاب کنیم؟
بازار تجهیزات سلامت محیط پر از مدل های متنوع است. دستگاه های تصفیه هوای خانگی مانند مدل های کوچک قابل حمل با باتری داخلی برای استفاده در خودرو یا اتاق کودک بسیار پرطرفدار هستند. مدل های بزرگ تر با فیلترهای چند لایه و خروجی هوا با پوشش بالا، برای بیمارستان ها و دفاتر بزرگ مناسب اند. همچنین انواع دستگاه های سنجش کیفیت هوا، رطوبت سنج های دیجیتال، ضدعفونی کننده های دستی و سیستم های UV در این دسته قرار می گیرند. برخی مدل ها قابلیت اتصال به وای فای و ارسال گزارش های لحظه ای دارند. برای افرادی که به دنبال بهترین کیفیت و عملکرد هستند، انتخاب مدل های چندکاره از تجهیزات سلامت محیط همیشه پیشنهاد می شود.
پشت پرده قیمت تجهیزات سلامت محیط؛ چه عواملی تعیین کننده هستند؟
قیمت تجهیزات سلامت محیط به عوامل متعددی بستگی دارد. برند یکی از مهم ترین فاکتورها است؛ برندهای معتبر معمولاً قیمت بالاتری دارند اما کیفیت و خدمات بهتری هم ارائه می دهند. ویژگی های فنی دستگاه مانند نوع فیلتر، توان تصفیه، قابلیت هوشمند، مصرف انرژی و قابلیت حمل نیز تأثیر مستقیم بر قیمت دارند. همچنین طراحی ظاهری، جنس بدنه و امکانات جانبی مانند اپلیکیشن موبایل یا نمایشگر لمسی از دیگر عوامل تأثیرگذار هستند. نوسانات نرخ ارز و وضعیت بازار نیز می توانند قیمت نهایی را بالا یا پایین ببرند. به طور کلی، هرچه دستگاه تجهیزات سلامت محیط کامل تر و با تکنولوژی بالاتری باشد، قیمت بالاتری نیز خواهد داشت.
از کجا بخریم؟ راهنمای خرید تجهیزات سلامت محیط از فروشگاه کیان داریا
اگر قصد خرید تجهیزات سلامت محیط را دارید، فروشگاه اینترنتی کیان داریا یکی از بهترین گزینه ها برای تهیه این محصولات به شکل تخصصی و مطمئن است. در سایت کیان داریا، می توانید انواع تجهیزات سلامت محیط را با اطلاعات کامل فنی، مشخصات دقیق، قیمت به روز و ضمانت اصالت کالا مشاهده و خریداری کنید. فرایند خرید در این فروشگاه ساده و سریع طراحی شده و امکان مقایسه محصولات و مشاهده تصاویر برای انتخاب بهتر نیز فراهم شده است. با توجه به تنوع محصولات موجود، کافی است نوع نیاز خود را مشخص کنید—مانند تصفیه هوا، ضدعفونی کننده ها یا دستگاه های سنجش کیفیت هوا—و بر اساس فضای مورد نظر و بودجه تان، محصول مناسب را انتخاب نمایید. ارسال سریع، پشتیبانی حرفه ای و قیمت رقابتی از مزیت های اصلی خرید از کیان داریا هستند.
این تجهیزات یک انتخاب هوشمندانه برای هر فرد یا سازمانی است که به سلامت خود و دیگران اهمیت می دهد. با خرید این تجهیزات، نه تنها کیفیت هوای محیط را بالا می برید، بلکه از بروز بسیاری از بیماری های تنفسی، آلرژی و مشکلات بهداشتی جلوگیری می کنید. تنوع، تکنولوژی بالا و کارایی فوق العاده این محصولات باعث شده اند تا یکی از پرطرفدارترین انتخاب ها در میان خانواده ها و مراکز درمانی باشند. اگر به دنبال راهی برای ارتقای سطح سلامت و بهداشت محیط خود هستید، همین حالا اقدام به خرید تجهیزات سلامت محیط از فروشگاه کیان داریا کنید.